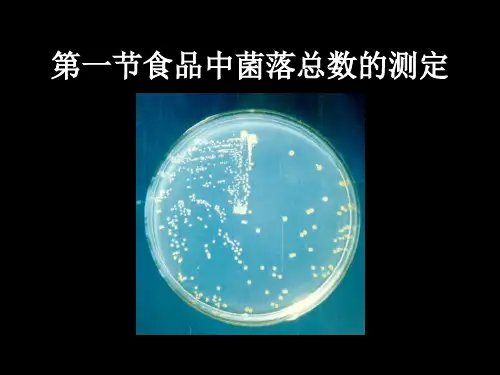

食品微生物学检验菌落总数培训
- 格式:ppt
- 大小:443.51 KB
- 文档页数:33

培训试题一、填空题(共35个空,共计70分)1、菌落总数:食品检样经过处理,在一定条件下(如培养基、培养温度和培养时间等)培养后,所得每g(mL)检样中形成的微生物菌落总数。
2、平板计数琼脂培养基的成分有胰蛋白胨、酵母浸膏、葡萄糖、琼脂、蒸馏水。
3、菌落总数小于100 CFU 时,按“四舍五入”原则修约,以整数报告.4、大肠菌群:在一定培养条件下能发酵乳糖、产酸产气的需氧和兼性厌氧革兰氏阴性无芽胞杆菌。
5、GB 4789.3-2016《食品安全国家标准食品微生物学检验大肠菌群计数》中第一法适用于大肠菌群含量较低的食品中大肠菌群的计数;第二法适用于大肠菌群含量较高的食品中大肠菌群的计数。
6、MPN法是统计学和微生物学结合的一种定量检测法.待测样品经系列稀释并培养后,根据其未生长的最低稀释度与生长的最高稀释度,应用统计学概率论推算出待测样品中大肠菌群的最大可能数。
7、GB 29921-2013《食品安全国家标准食品中致病菌限量》n为同一批次产品应采集的样品件数;c为最大可允许超出m值的样品数;m为致病菌指标可接受水平的限量值;M为致病菌指标的最高安全限量值。
8、无菌生理盐水的制法:称取8。
5g氯化钠溶于1000mL蒸馏水中,121℃高压灭菌15min.9、霉菌和酵母平板计数法的培养过程:琼脂凝固后,正置平板,置28±1℃培养箱中培养,观察并记录培养至第5天的结果。
10、菌落总数的培养过程:待琼脂凝固后,将平板翻转,36±1℃培养48±2h。
11、霉菌和酵母平板计数法:若空白对照平板上有菌落出现,则此次检测结果无效。
12、大肠菌群平板计数法:在固体培养基中发酵乳糖产酸,在指示剂的作用下形成可计数的红色或紫色,带有或不带有沉淀环的菌落.二、简答题(共1题,共计30分)GB 2749-2015《食品安全国家标准蛋与蛋制品》中液蛋制品的菌落总数和大肠菌群的微生菌落总数:25g(ml)样品+225ml稀释液,均质→10倍系列稀释→选择2~3个适宜稀释度的样品匀液,各取1ml分别加入无菌培养皿中→每皿中加入15~20ml平板计数琼脂培养基,混匀→培养→计数各平板菌落数→计数菌落总数→报告大肠菌群(平板计数法):25g(ml)样品+225ml稀释液,均质→10倍系列稀释→选择2~3个适宜稀释度的样品匀液,倾入VRBA平板(36±1℃培养18~24h)→计数典型和可疑菌落→BGLB肉汤(36±1℃培养24~48h)→报告结果。


食品微生物检验中菌落总数测定的注意事项食品微生物检验中菌落总数测定的注意事项1菌落总数及测定菌落是指细菌在固体培养基上生长繁殖而形成的能被肉眼识别的生长物,它是由数以万计相同的细菌集合而成。
当样品被稀释到一定程度,与培养基混合,在一定培养条件下,每个能够生长繁殖的细菌细胞都可以在平板上形成一个可见的菌落。
菌落总数就是指食品检样经过处理,在一定条件下(如需氧性质、培养基成分、pH、培养温度和时间等) 1 mL ( g)检样中所含菌落的总数。
菌落总数测定是用来判定食品被细菌污染的程度、食品的新鲜度及卫生质量,它反映食品在生产、加工、销售过程中是否符合卫生要求,以便对被检样品做出适当的卫生学评价。
也可以应用这一方法观察食品中细菌的性质以及细菌在食品中繁殖的动态,菌落总数的多少在一定程度上标志着食品卫生质量的优劣[ 1 ] 。
2菌落总数测定中的注意事项2. 1所用器皿及稀释液2. 1. 1检验中所用玻璃器皿,如培养皿,吸管、试管、移液器的吸头等必须是完全灭菌的,并在灭菌前彻底洗涤干净,不得残留有抑菌物质。
2. 1. 2用作样品稀释的液体,每批都要有空白对照。
如果在琼脂对照平板上出现几个菌落时,要查找原因,如可通过追加对照平板,以判定是空白稀释液,用于倾注平皿的培养基,还是平皿、吸管或空气可能存在的污染。
2. 1. 3检样的稀释液一般用灭菌盐水,如果对含盐量较高的食品(如酱品等)进行稀释,则宜用蒸馏水。
做醋时用20% ~ 30%碳酸钠调pH 至中性。
2. 2检样的稀释2. 2. 1检样稀释时,应以无菌操作称取(或量取)有代表性的样品25 g (或mL ) , 剪碎放于含有225 mL灭菌稀释液的玻璃瓶内(瓶内预置适当数量的玻璃珠) ,经充分振摇作成1: 10 的稀释液。
如系肉、鱼等固体样品,先用自来水把表面冲洗干净,取可食部分(即鱼肉)剪细加入稀释液后,置均质器中以8 000 ~ 10 000 r /min 速度处理1 min,使做成均匀的1: 10稀释液。



食品中菌落总数的测定实验报告一、实验目的1、学习并掌握食品中菌落总数测定的基本原理和方法。
2、熟练使用无菌操作技术和相关仪器设备。
3、了解食品卫生质量的重要性,以及菌落总数在评价食品卫生状况中的意义。
二、实验原理菌落总数是指食品检样经过处理,在一定条件下培养后(如培养基成分、培养温度和时间、pH 值、需氧性质等),所得 1g 或 1ml 检样中所含细菌菌落的总数。
菌落总数主要作为判定食品被细菌污染程度的标志,也可以应用这一方法观察细菌在食品中繁殖的动态,以便对被检样品进行卫生学评价时提供依据。
三、实验材料和设备1、实验材料各种待检食品样品(如牛奶、面包、水果等)营养琼脂培养基无菌生理盐水2、实验设备恒温培养箱高压蒸汽灭菌锅超净工作台无菌吸管(1ml、10ml)无菌培养皿电子天平均质器四、实验步骤1、样品的采集和处理以无菌操作采集具有代表性的食品样品,放入无菌容器中。
对于固体食品,使用均质器将其均质成匀浆;液体食品则直接吸取进行稀释。
2、稀释样品用 1ml 无菌吸管吸取 1ml 样品匀浆或液体样品,注入盛有 9ml 无菌生理盐水的试管中,制成 1:10 的样品稀释液。
用 1ml 无菌吸管吸取 1:10 稀释液 1ml,沿管壁缓慢注入盛有 9ml 无菌生理盐水的试管中,振摇试管混合均匀,制成 1:100 的稀释液。
以此类推,进行适当的梯度稀释。
3、接种选择 2-3 个适宜稀释度的样品稀释液,每个稀释度分别吸取 1ml 注入无菌培养皿中。
及时将 15-20ml 冷却至 46℃左右的营养琼脂培养基倾注于培养皿中,并转动培养皿使其混合均匀。
4、培养待琼脂凝固后,将培养皿翻转,放入 36±1℃的恒温培养箱中培养48±2h。
5、菌落计数培养结束后,取出培养皿,计数每个平板上的菌落数。
菌落计数时,应选取菌落数在 30-300 之间的平板进行计数。
若有两个稀释度的平板菌落数在 30-300 之间,应按两者菌落总数之比值来决定。

一、填空题(共35个空,共计70分)1、菌落总数:食品检样经过处理,在一定条件下(如培养基、培养温度和培养时间等)培养后,所得每g(mL)检样中形成的微生物菌落总数。
2、平板计数琼脂培养基的成分有胰蛋白胨、酵母浸膏、葡萄糖、琼脂、蒸馏水。
3、菌落总数小于100 CFU 时,按“四舍五入”原则修约,以整数报告。
4、大肠菌群:在一定培养条件下能发酵乳糖、产酸产气的需氧和兼性厌氧革兰氏阴性无芽胞杆菌。
5、GB 4789.3-2016《食品安全国家标准食品微生物学检验大肠菌群计数》中第一法适用于大肠菌群含量较低的食品中大肠菌群的计数;第二法适用于大肠菌群含量较高的食品中大肠菌群的计数。
6、MPN法是统计学和微生物学结合的一种定量检测法。
待测样品经系列稀释并培养后,根据其未生长的最低稀释度与生长的最高稀释度,应用统计学概率论推算出待测样品中大肠菌群的最大可能数。
7、GB 29921-2013《食品安全国家标准食品中致病菌限量》n为同一批次产品应采集的样品件数;c为最大可允许超出m值的样品数;m为致病菌指标可接受水平的限量值;M为致病菌指标的最高安全限量值。
8、无菌生理盐水的制法:称取8.5g氯化钠溶于1000mL蒸馏水中,121℃高压灭菌15min。
9、霉菌和酵母平板计数法的培养过程:琼脂凝固后,正置平板,置28±1℃培养箱中培养,观察并记录培养至第5天的结果。
10、菌落总数的培养过程:待琼脂凝固后,将平板翻转,36±1℃培养48±2h。
11、霉菌和酵母平板计数法:若空白对照平板上有菌落出现,则此次检测结果无效。
12、大肠菌群平板计数法:在固体培养基中发酵乳糖产酸,在指示剂的作用下形成可计数的红色或紫色,带有或不带有沉淀环的菌落。
二、简答题(共1题,共计30分)GB 2749-2015《食品安全国家标准蛋与蛋制品》中液蛋制品的菌落总数和大肠菌群的微生菌落总数:25g(ml)样品+225ml稀释液,均质→10倍系列稀释→选择2~3个适宜稀释度的样品匀液,各取1ml分别加入无菌培养皿中→每皿中加入15~20ml平板计数琼脂培养基,混匀→培养→计数各平板菌落数→计数菌落总数→报告大肠菌群(平板计数法):25g(ml)样品+225ml稀释液,均质→10倍系列稀释→选择2~3个适宜稀释度的样品匀液,倾入VRBA平板(36±1℃培养18~24h)→计数典型和可疑菌落→BGLB肉汤(36±1℃培养24~48h)→报告结果小升初数学模拟试卷姓名得分。